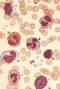
aok:targyak:orvosi_elettan_a-d:gyakorlat:versejt.jpg

Médiakezelő
Névterek
Névtér kiválasztása
Médiafájl kiválasztása
Fájlok itt: aok:targyak:orvosi_elettan_a-d:gyakorlat
- versejt.jpg
- 420×626
- 2024/11/24 15:50
- 124.9 KB
Fájl
- Megtekintés
- Szerkesztés
- Korábbi változatok
- Dátum:
- 2005/06/01 13:47
- Fájlnév:
- versejt.jpg
- Formátum:
- JPEG
- Méret:
- 125KB
- Szélesség:
- 420
- Magasság:
- 626
- Hivatkozások:
- Minőségi vérkép készítése


